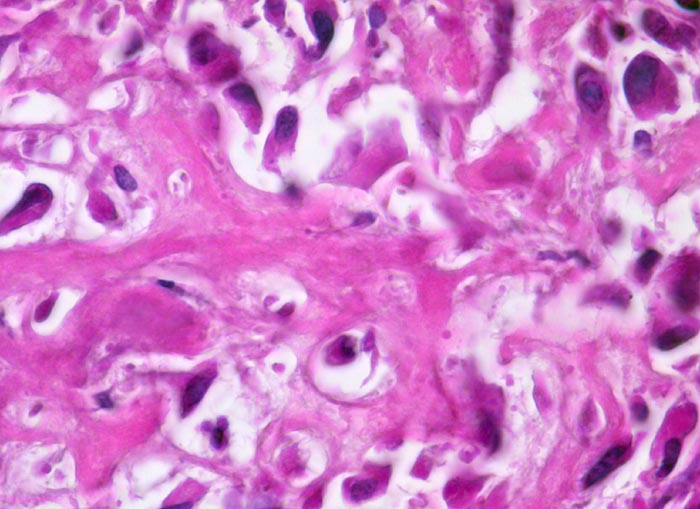

PathoPic – image database / PathoPic ID 4789 - Osteosarkom
de
Diagnose
Osteosarkom
Diagnose Gruppe
maligner Tumor
Topographie
Knochen, Femur
Topographie Gruppe
Knochen, Knorpel, Gelenke
Beschreibung
Klinik
16 jähriger Jugendlicher mit seit mehreren Wochen bestehenden belastungsunabhängigen Schmerzen im distalen Femur rechts oberhalb des Knies (Metaphyse). Im Röntgenbild irreguläre Verdichtung, zum Teil auch Aufhellung der ursprünglichen Knochenstruktur mit Zerstörung der Corticalis und spiculaartige (=sonnenstrahlenähnliche) Periostreaktion. Im Serum erhöhte alkalische Phosphatase.
Kommentar
Der Nachweis von Osteoid, das von atypischen Zellen gebildet wird, ist das wichtigste Kriterium für die Diagnose eines Osteosarkoms. Osteosarkome können aber auch auf weiten Strecken ausschliesslich chondroide oder fibröse Matrix bilden und dann ein Fibrosarkom, Chondrosarkom oder ein malignes fibröses Histiozytom imitieren.
Bilder Typ
Histologie
Vergrösserung
630
Alter
16
Geschlecht
männlich
Datum
Ersteintrag: 08.05.2002